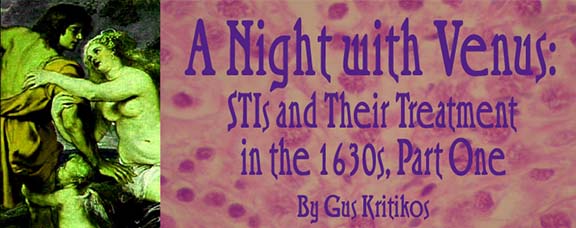
gg2633.jpg

Sexually transmitted infections (formerly called venereal diseases) caused a surprising amount of discomfort, loss of fertility, madness and even death in the early modern era. There was a lack of understanding of the diseases, of the corresponding public health measures that should have been in effect, and of reliable treatments. Advances in bacteriology and serology starting in the 1890s in this time line provided the first consistent ability to diagnose the infections early in their course. Effective treatment started a decade later, with the discovery first of arsenicals for syphilis. Several decades later the sulfa class drugs and finally penicillin and chloramphenicol were developed. All of these drugs are (by canon) producible with 1630's technology and guidance from up-time sources. It is important to note that one of the most critical tenets of public health is that treatment is needed for not only the presenting patient, but also all identifiable intimate contacts of that patient.
Please note that any prospective dates given in this article are my own personal first approximation SWAGs, and based on my estimation of the progress from 1631 to the 1660 time frame as compared to the 1900 to 1970 time frame in this time line. Iver Cooper's excellent article on Organic Chemistry (Industrial Alchemy Parts III and IV) contains references to the antibiotics in canon, and I have adapted those as the baseline.
Syphilis was named for a shepherd in the 1530 epic poem, "Syphilis, or the French disease" by Girolamo Fracastoro, an Italian physician trained at Padua. As a disease, syphilis was first characterized in 1494 with an outbreak in Naples that was linked to some of Columbus' crewmen. Other names for the disease include the Great Pox (to distinguish it from Small Pox), the French Pox (by the English, Italians and Germans), the English Disease by the French and South Sea Islanders, and the Turkish Disease by the Russians. Notice the pattern of blaming the disease on one's enemies!

The causative agent, Treponema pallidum, is a pale, spiral shaped, mobile single celled organism that normally lives in humans. Various ideas of the source of the original infection have been proposed, with arguments about the antiquity of this disease having extended for several centuries. Currently, there are two competing ideas, first, the Old World theory, where syphilis is derived from the skin disease bejel, which has been known since antiquity, mostly in the western end of the Mediterranean. It is caused by a Treponema that is closely related to T. pallidum. It, like most of the New World forms, is a skin infection not requiring intimate sexual contact. There is some suggestion that bejel may have been confused with leprosy at times, as both produce painless ulcers, can result in scarring with loss of sensation, leading to further risk of damage from recurrent minor trauma, and both cause soft tissue and bony destruction over time. Bejel is more transmissible than leprosy, and occasionally undergoes spontaneous cure, both of which are arguments towards bejel being the Biblical Tzaraath, not what we know as leprosy today. Possible evidence of Treponema related bony changes have been noted in pre-Columbian skeletons from Pompeii, among other places.
The New World, or Columbian, theory which theorizes that Columbus and his men brought the disease back after sexual contact with New World natives, is related to various treponemal New World tropical diseases, including yaws and pinta. As with bejel, these are skin infections not requiring intimate genital contact. Recent research tends to favor Columbian origin, as genetic testing suggests that syphilis is more closely related to yaws than bejel, and there appears to be an intermediate form (between yaws and syphilis) that occurs along the northeast coast of South America.
Wherever syphilis originated, the epidemic form was noted with numerous cases starting in the 1493-94 timeframe, and continued unchecked through the middle 1500s, and then, in a somewhat milder form, through the late 1800s. While the treponemal skin infections show evidence of having been long associated with humans, the epidemic suggests that during the change of the tropical form to a venereal form, suitable for transmission in the colder areas of Europe, a more aggressive subtype was selected. An interesting correlation can be noted here, as when experimental rabbits are partially shaved and then infected with T. pallidum, the shaved (cooler) areas of the rabbit's body show substantially more and worse lesions than the fully furred areas.
Similar problems with an aggressive disease were noted in the first stages of the AIDS epidemic, but the public health authorities in the 1632 universe, lead by Dr. Balthazar Abrabanel, are determined to avoid the mistakes made in the 1980s in this time line. Like AIDS and the viral hepatitis infections, syphilis can be blood borne, and this will be a major threat to the blood supply in the early stages of blood banking.
Several stages are associated with syphilis, which is one of the most important diseases in the 1632 time line. In the primary infection, a flat red patch (macula) is noted at the point of infection. This develops into a painless ulcer with a raw, red base, hard, smooth edges (called a chancre) and often no other symptoms. There is a latent period of 10 days to 3 months, with an average 3 weeks from the time of exposure to the appearance of the chancre. The patient is mildly infectious after the appearance of the ulcer. One to six months after the initial infection, with an average 6-8 weeks, the secondary stage starts with the appearance of a rash that occurs anywhere on the body. This is one of the very few rashes that shows up on the palms of hands and the soles of feet, and any patient in the 1632 universe with a rash on the palms and soles will be considered to have syphilis until proven otherwise.
In this time line, the rash is reddish pink and appears evenly on both sides of the body, extending to the extremities. In the 1630s, the rash was more pronounced, often with open sores that gave rise to the name "Great Pox" to differentiate it from smallpox. Flat, pale, fleshy masses, called condyloma lata, occur in skin folds and other moist areas of the body and, like the palmar rash, are considered diagnostic for the disease. Other signs of generalized inflammation including swollen lymph nodes, fever, sore throat, malaise and headache also occur. In about 2% of the cases in any stage of the disease, a form of meningitis may occur, which is a dire sign. Because infective treponema can be found in the rashes, condylomata and ulcers, the secondary stage is the most infective stage of the disease. An interesting sign is a patchy loss of hair on the head, where the rash interferes with hair growth, that occurs in about 5% of the patients. The outer edges of the eyebrows can also be affected.
The latent stage starts with resolution of rash and healing of any active ulcers and disappearance of any condylomata, which may occur two weeks after the rash starts, but is most often a month or more later. At this point, there is little physical evidence of the disease, however the patient remains infective, but much less so than secondary stage. The progression of the infection from here shows that roughly one quarter of the cases result in spontaneous resolution, another quarter remain in the latent state for long periods of time (possibly the rest of their life), and ultimately one half progress to the tertiary stage, from one year to a decade or more later.
It is at this stage that syphilis becomes known as "The Great Imitator," because the presentation of the disease is so variable. Rashes may occur across any area of the body, and again occur on the palms and the soles. In the 1630s, these rashes also included open sores. Gummas, formed of reactive granuloma tissue, occur in many areas of the body, most typically in the liver and on the face. These non-cancerous tumors (swellings) are firm, rounded, and not tender. They may resolve spontaneously, leaving either a scar or a lump, or may persist for years. Some of them will cause bone or cartilage damage, leading to such problems as collapsing of the nose or ears. Heart failure due to muscle damage, aortic arch aneurysms (which were noted in Sherlockian canon), stomach ulcers, nose bleeds and kidney damage were also common.
Neurosyphilis was one of the most feared complications of long-term syphilis, and was ultimately a terminal condition prior to the advent of antibiotics. While most common in the tertiary stage, neurosyphilis could actually occur in any stage. Common findings included tabes dorsalis (a wide based gait with "slapping" steps due to the loss of sensory feedback from the legs and feet), and Argyll Robertson pupils (or "whore's eyes," described as "accommodating, but not reactive" because the pupils of the eyes will narrow as the patient tries to track a finger moving closer to the patient's face (accommodation), but will not narrow when a light is flashed into the eyes (reactivity)). Ultimately, psychosis, insanity and a particular form of flaccid (limp) paralysis called general paresis of the insane will occur, leading to death. In this time line, the connection between general paresis and syphilis was not made until the late 1850s and finally confirmed by the finding of active spirochetes in damaged brains in 1913.
A history of sexual contact with known infected persons or of birth to an infected mother (perinatal transmission) is the most important single factor in the diagnosis of syphilis until the development of serological tests for syphilis (STS), which will probably be sometime after 1636. Secondary history findings of the patient having any other sexually transmitted disease, or having what I will politely call a "rakehell" history, will be as highly suspicious for syphilis exposure in the 1630s as it is today. Additionally, a history of receiving a blood transfusion, followed by typical physical findings, will be highly suspicious for syphilis.
I have already discussed the physical findings above, starting with the chancre, the rash (especially on the palms and soles), the "Great Pox" and progressing to the findings of neurosyphilis.
Serologic tests for syphilis (STS) have been the mainstay of screening for syphilis in this time line since the development of the Wasserman test prior to WWI. All of the screening tests are based on the cross reaction of beef cardiolipin antigen (diphosphatidyl glycerol, an alcoholic extract of beef heart that has the same structure as part of the treponema cell membrane), and are thus referred to as non-treponemal antigen tests.
It must be noted that these tests are not specific for syphilis, but can also cross react to other antibodies produced by the body in response to autoimmune conditions such as rheumatoid arthritis, and a number of other infections, including non-syphilis treponemal infections, tuberculosis and viral diseases. Additionally, because of the peculiarities of serologic testing and the relationship between the antibodies and antigens as they are tested, high levels of antibodies can result in a false negative test, even in a highly infectious patient. If there is a high degree of suspicion, the patient's serum will be diluted (several times if needed) and retested.
The non-treponemal serologic tests for syphilis (STS) fall into two broad categories, hemolysis and flocculation.
Hemolysis testing, most notably the Wasserman test, is where sheep red blood cells (sRBCs) are mixed with the cardiolipin solution, which results in the blood cells being "tagged" with the cardiolipin. Antibodies in the serum being tested cause the sRBCs to break down or "hemolyse" in a process known as complement fixation. This hemolysis is measured on a scale from zero to four depending on the measurement of free hemoglobin in the solution after all of the sRBCs have settled out. Syphilis patients can expect to remain at least weakly positive for the rest of their lives. Several modifications of Wasserman's original test were developed before hemolysis testing was superseded in the 1940s by the development of flocculation testing.
Flocculation tests, developed initially by Hinton, and further developed to the Venereal Disease Research Laboratory (VDRL) test, and then the Rapid Protein Reagin (RPR) test, are easier to perform, as well as both more sensitive and more specific than the hemolysis tests. These tests depend on antibodies cross-linking small particles that have been tagged with cardiolipin, resulting in the fluid changing from a smooth appearance to a clumpy one. The big difference between the VDRL and the RPR tests is that RPR substrates are cross-linked in such a way as to allow for testing without a microscope. Both of these tests can be used with serum dilutions to quantify the degree of infection (titration or "titer"), and a four-fold decrease in the titer (say from a dilution of 1 part serum to 32 parts of saline to 1 part serum to 8 parts of saline) indicates that the patient is recovering from the disease. The RPR test, in particular, is suitable for rapid screening of blood donations, as well as prenuptial and prenatal testing.
The VDRL test can be also used with Cerebral Spinal Fluid (CSF—fluid around the brain and spinal cord) obtained by a "spinal tap" for the diagnosis of and evaluation of treatment for neurosyphilis. This is needed because the blood brain barrier, especially if inflamed from infection, will not allow the passage of the antibodies we want the test to find. As a result, someone may have an active, life-threatening neurosyphilis but without active infection elsewhere in the body the serum tests may well be negative.
The basic serologic tests for syphilis will probably be within 1630's tech after 1633, as the public health authorities will be pressing for their urgent development, to secure the blood supply if for no other reason. I expect that the hemolysis type tests will used only long enough to develop the easier to use flocculation tests, which should not take more than another year once the cardiolipin is isolated. I am working up a more detailed timeline on serology and blood banking, which will have more detailed information on this subject.
The other class of serological testing for syphilis either uses live treponema organisms (immobilization tests) or specific antigens derived from treponema (FTA-ABS, and TPHA), and are thus more sensitive and specific for treponemal infections. Because T. pallidum will survive in rabbits, and form lesions that can be "harvested" for live treponema, the treponemal immobilization test may be available in the 1633 time frame, but it is a time consuming (approximately a full day) and fairly complex test. As an interesting aside, it was noted prior to 1973 that rabbits infected with the milder organisms of yaws initially developed skin lesions consistent with that disease. However, as other rabbits were infected from the initial carriers, more invasive lesions, more consistent with syphilis were noted, adding to the early arguments for the Columbian theory. I do not expect the other specific tests to be available until 165x based on expected expansion of tech based on developments in this time line. Look for more details in the serology and blood-banking article.
Dark field microscopy of scrapings from open sores will be an important diagnostic and confirmation test for quite a while in the 1630s. This requires a special condenser set (light source) on an otherwise standard laboratory microscope, a number of which should be at the high school biology laboratory. If the laboratory does not have dark field or phase contrast condensers, the descriptions in the various encyclopedias should be enough for up-time machinists and down-time lens grinders to manufacture those items in short order, even as early as late 1632. Some special staining techniques are available in this time line that allow a technologist with a conventional microscope to identify the treponemal organisms, but these are more suitable for pathologic specimens (surgical tissues, post mortem brain samples, etc). The dark field technique using wet preparations made from scrapings of chancres or sores in rashes needs to be done rapidly on fresh specimens. While this takes some experience on the part of the examiner, it is faster and easier than the special stains.
Metallic treatments were the first treatments developed in OTL, with mercury being current in 1632. This type of treatment will be mostly bypassed in Grantville, but I expect that they will continue to be used by areas not able to initially support adequate production of antibiotics and not able to obtain stocks of antibiotics from elsewhere. Both metallic mercury and the inorganic salts of that metal were used as early as 1025 and are mentioned in Avicenna's textbook. It wasn't until Prof. Paul Ehrlich's collaborators developed Salvarsan (compound 606, as there were 605 other organic compounds of arsenic tested before hitting on the effective one) in 1906, the same year that Dr. Wasserman described his test for syphilis. Refinement to the point of marketing the drug took another four years or so, and the drug was released in 1910. It is well within 1630's tech once the structure and up-time tricks of making it are known. Both of the metallic systems require long term (months to years) treatment for full effect. Additionally, while Salvarsan is much less toxic than mercury, both cause significant toxicity in humans, and both depend on treponema being more sensitive to the heavy metal poisoning than humans. A point raised by Iver Cooper is that the information on producing Salvarsan is limited in Grantville, and that, in this time line there were many problems with the conversion of the drug from the shipped form into a form that can be delivered to the patient through an IV. Based on his comments, and further reading on the subject, I now expect that penicillin will be available in quantity well before Salvarsan can be produced.
It was known for some years by 1632 that the use of heat treatments along with mercury treatments seemed to slow the progression of advanced cases of syphilis. This was usually delivered by using a "steam cabinet" type of apparatus (enclosing the body, but leaving the head exposed) with a bowl of mercury in the cabinet. Additionally, deliberate infection with malaria, shown in 1917 to slow or even reverse the progression of neurosyphilis in OTL, won the Nobel Prize for Wagner-Jauregg in 1927. Given the up-time information of how malaria is spread, this treatment will also be well within 1630's tech by the end of 1632. Various forms of pyrotherapy may also be of use with antibiotics in severe cases. Support for this includes the rabbit shaving experiments, and the point that the tropical forms are much more indolent than syphilis was in the 1500-1630's time frame.
Chloramphenicol will be the first reasonably safe treatment for syphilis in the 1630s. Easiest dosing is orally, but it can also be used intramuscularly (IM) or intravenously (IV). Dosages are 50 milligrams per kilogram of body weight per day (mg/kg/day) for moderate infections, up to 100 mg/kg/day for more serious infections. Total doses for adults are about 500-1000 mg per dose, four times a day. Interestingly enough, chloramphenicol may work better than penicillin for severe cases of neurosyphilis due to improved penetration into fluid around the brain (CSF). Due to factors involved in the metabolism of the drug in the liver and elimination of the drug through the kidneys, generally the preference of therapy is oral then IM, and then IV. Due to these same factors, the blood concentration of the IV medication is only about one third of the others. Syphilis can be expected to be sensitive enough that the course of therapy will be a few days to a couple of weeks at the most, compared to the months or years of the metallic compounds.
Penicillin is, in this time line, the definitive treatment for syphilis, especially for pregnant women. In early cases, primary or secondary, the treatment is a simple, one dose of Benzathine Penicillin LA (long acting), 1.2 million Units, usually given IM (in the buttock). Later cases, late secondary or tertiary, will need several doses over days to weeks of IV or IM treatment. Even today, T. pallidum remains exquisitely sensitive to penicillin, and as stocks of this drug increase, it will essentially replace all others for the treatment of syphilis, unless a patient is actually allergic to the drug. Even then, there are techniques of desensitization that can be used to allow appropriate treatment.
Probenicid is not an antibiotic itself, but by actions on the kidney, it reduces elimination of penicillin class drugs from the body, extending the effectiveness of the antibiotics and thus conserving the initial limited stores. Even after penicillin is freely available, Probenicid will continue to be used with oral forms to increase their effectiveness.
The tetracycline group and streptomycin, when available, will be the primary alternate treatments for syphilis infections, especially in non-pregnant penicillin-allergic patients. That availability will depend, however, on finding the appropriate species of Streptomyces, a soil organism of the Actinobacter group. Most of the tetracyclines can be given orally, but streptomycin is only given IM in this time line.
Frequently, a Jarisch-Herxheimer reaction will occur as the antibiotic kills the treponema. This is due to the release of cell components (endotoxins) that cause fevers, chills, malaise and rashes and is not an allergic reaction. This normally occurs within 24 hours of initiation of treatment and resolves within another 24 to 48 hours. The reaction occurs in 50% of treated primary cases and 90% of treated secondary cases, the more aggressive form of syphilis seen in the 1630s could be expected to cause even more significant reactions in an even higher percentage of the patients. Teaching the patients and their families to expect this problem will go a long way to prevent a significant scare reaction from the families, which would probably result in a nasty backlash.

Prevention of disease in this time line (from the 1906 Wasserman test up to the 1940s widespread use of penicillin for treatment), by the consistent and widespread use of prenuptial and prenatal testing, went a long way to reducing the transmission of disease. "Safer sex" and the use of latex condoms do help prevent transmission, however, since syphilis can infect any area of the body that has been in contact with an active infection, antibiotic cure will be much more effective. I expect that the down-time authorities will be much more willing to use physical quarantine of syphilitics and other folks with chronic, incurable infectious diseases much more readily than has happened in this time line since the 1950s. I base this on laws such as the Scots Grandgore act of 1497, where known syphilitics were sent to the Island of Inchkeith for the rest of their lives.
Untreated, chronic syphilis infections will result in bone, joint and soft tissue damage, at least partially from the body's reaction to the infection. About one case of six infections develop gummas, inflammatory masses which can cause pressure effects and damage to bones and joints as well as soft tissues. One of the classic situations results in damage to the bridge of nose, causing a "ski slope" curve to that organ. There can also be significant joint damage from loss of sensation as well as the mass effect. About one case in ten will develop heart and blood vessel damage as noted in Sherlockian canon (a syphilitic aortic aneurysm was a major plot point in "A Study in Scarlet"). In addition to marked aortic aneurysms (abnormal balloon like weakening of the largest blood vessel in the body), significant heart enlargement and heart failure is known to occur, and is a frequent cause of death in late stage syphilis. About one case in fifteen will end up developing neurosyphilis, with the resulting central loss of sensation as shown by tabes dorsalis and Argyll Robertson Pupils, and ending up with madness and general paresis if untreated.
Congenital Syphilis displays multiple problems including various birth defects as well as a marked increase in preterm births and miscarriages. This was more common prior to the advent of effective STS and treatment in the First and Second Worlds, and continues to this day in the Third World. The initial situation in the 1630s is most similar to that of the Third World today. Early congenital syphilis (age less than 2 years at presentation) may appear as an exaggerated secondary stage, with a rash, mucosal lesions and enlargement of the liver and spleen. Notched teeth (Hutchinson's incisors) and problems with walking due to loss of nerve function and eventually joint problems (Clutton's joints), show up in the first 18 months or so. A number of characteristic facial changes have been documented over the years, including enlargement of the forehead (frontal bossing), palate changes, and saddle nose. Eighth nerve damage resulting in deafness may be present in less than 5% of the cases. Fortunately, congenital syphilis may be prevented by treatment of the mother, which is the reason for the requirement for prenatal testing.
A number of prominent persons who are relevant to 1632 are suspected of having advanced syphilis, including Henry VIII, Ivan the Terrible, and Henry Stuart, Lord Darnley.
Unlike syphilis, the infective organism of gonorrhea, Neiserria gonorrhoeae, also known as the gonococcus, only infects specific types of mucus membranes, which makes it a bit easier to prevent. Other common names for the infection include "the clap," "the drip," and "the pipe bending pee pains." There are several forms of gonococcal infections, depending on the area of infection. These include female cervical, urethral, tonsillar, and rectal forms in both sexes. Men pass the infection to women at a rate of 50-70% per episode of unprotected vaginal intercourse, while the reverse rate is only about 25% effective per episode.
Contact tracing is one of the most important forms in history for this infection. Since the majority of women have no history of problems with infection, finding contacts (female and male) of symptomatic males is of primary importance. Routine screening of women at the time of physical exam ("pap and pelvic" when those are resumed), finds many cases (of both gonorrhea and Chlamydia) in this time line. The most important presenting complaints in men involve a purulent (pus) discharge from the penis (approximately 90% of cases) and marked pain on urination (75-80% of cases). The pain has been described as "peeing broken glass," or "pipe bending." These symptoms start between 3 and 10 days after exposure. Roughly 10% of the male cases have few or no symptoms, and it is felt that these male cases contribute to the continued spread of the disease.
In men, the classic discharge can be demonstrated by "milking" the penis (after retracting the foreskin of uncircumcised males), and then obtaining a swab for Gram's stain and culture. Mild irritation to the meatal opening may also be noted. Few other signs or symptoms are noted in otherwise uncomplicated infections. More serious cases may present with swelling or tenderness of the scrotum, indicating that epididymus (part of the tube between the testicle and the urethra) has become inflamed, either from the gonococcus or from a concurrent infection with another STI.
In women, there may be a similar purulent discharge from the cervix, from the urethra or from one or more of the various accessory glands of the female genitalia. Again, in mild disease, there may not be any other significant findings.
Concurrent infections of gonococcus and Chlamydia (see below) are so common that if there is evidence of one type of infection, treatment for both should be undertaken.
Classically, the discharge from the afflicted male's urethra is stained using Gram's technique, and show small, paired cocci (round bacteria), that are actually inside the white blood cells. If the female has a urethral discharge, it will be useful to Gram stain that material. However, because of the wide variety of normal bacterial flora in the throat, vagina and rectum, trying to stain material from those areas looking for these bacteria is useless.
If there is a suspicion of an infection, a quick microscopic examination of the patient's urine using a technique sometimes called a "split stream specimen," where two and sometimes three specimens are collected from a single urination, has the ability to quickly screen for a number of different urinary tract infections in both men and women. The specimens are obtained from the first, middle, and occasionally the final part of the urine stream. Part of each specimen is centrifuged to concentrate any pus, bacteria and/or sediment, and another portion is reserved for culture if indicated. If there are a large number of white blood (pus) cells in the initial urine specimen, but not in the middle or last parts, then urethritis is the most probable diagnosis. Pus in the middle portion of the specimen indicates an acute bladder infection, and pus, especially associated with certain types of crystals, in the last portion of the specimen can indicate chronic bladder or kidney problems. Gram's staining of the uncentrifuged second portion of the specimen can help different the different kinds of bladder infections, and offer predictions as to what the urine culture might be expected to show.
The use of urine screening to help decide further testing is used frequently in this time line, admittedly mostly with urine dipsticks. It is well documented as a technique, and has the advantage of being relatively simple, fast and available at the point of care. While not commonly used as such in this time line, it can be used as a quick test of cure after treatment (supplementing repeat cultures), something that will help prevent missed relapses or reinfections. Clearing of the discharge in both men and women is a good indicator of cure.
A sterile swab or wire loop is used to transfer a small portion of the discharge or urine onto so-called "chocolate Agar" in order to make a more definite diagnosis. Chocolate agar is classically made by the addition of sheep's blood to a standard agar mixture and then slowly heating the mixture to 56 degrees C before making the plates. The antibiotics added to chocolate agar to make the more specialized Thayer Martin agar will probably not be available until the mid-1640 time frames, which means one or more repeat "sub cultures" might need to be made to finish making the diagnosis.. After swabbing the material on the plates, the plates are placed in a sealable jar, a lit candle is placed in the jar and the jar is sealed. The candle will snuff itself out in a few minutes, leaving an atmosphere that is moist and enriched in carbon dioxide at the expense of the oxygen in the jar. This "candle jar" technique is essential in preferentially promoting the growth of Neiserria species over most other bacteria. There are several other tests that will need to be made on the isolated bacteria to confirm the diagnosis, including the oxidase, and peroxidase tests; and sugar fermentation studies, but those tests are all within the capability of 1630's tech, as they were developed in the 1900-1930 time frame.
Chloramphenicol will probably be the first line of treatment until adequate stores of penicillin are available. In this time line, the gonococcus was one of the more active bacteria in developing antibiotic resistance, perhaps second only to the common Staphylococcus. It was less than twenty years between the introduction of penicillin treatment for gonorrhea and the first cases of resistant forms being found during the Southeast Asian Conflict. This was as much due, like most bacterial development of resistance, to incomplete treatment with, inadequate dosages of, and/or inappropriate use of antibiotics. The use of probenicid will reduce the chance of resistance developing by extending the time that there is an effective concentration of penicillin class drugs in the system, and allows the use of either IM or oral penicillin or amoxicillin. When available, an advanced cephalosporin may also be used to treat the gonococcus, however, follow up with a tetracycline class drug is also needed to treat the common Chlamydia co-infection.
Silver nitrate or chloramphenicol eye drops at birth will prevent a possibly blinding infection called opthalmalagica neonatorum.
As noted above, the first resistant strains were noted in the 1960s, and the frequency of antibiotic resistance has continued to increase ever since, probably due to under treatment of gonorrhea in Third World countries. There will be public health efforts to combat this with a combination of more aggressive case tracking, an emphasis on adequate initial treatment, and follow up visits for test of cure.
Latex condoms are effective in preventing transmission, as is advising patients to abstain from sexual activity for at least seven days after treatment of both/all parties involved. The reported price of rubber in the 1630s will be on the order of a gram of rubber for a gram of silver, so condoms will not be cheap. If I understand the time line correctly, condoms will be available on at least a limited basis, by the end of 1634. This is at least partially due to the efforts of the military (which has uses of condoms beyond that of the common prophylactic practices).
Untreated, gonococcal infection can spread throughout the body. This is more common in women than in men because of the ease that the infection can spread inside the body cavity. In a small, but significant, segment of the infected female population, Fitz-Hugh Curtis syndrome, typified by inflammation of the capsule around the liver, right upper abdominal pain radiating to the right shoulder, abdominal tenderness, and intra abdominal scarring (adhesions) occurs. While painful, Fitz-Hugh Curtis syndrome is more important as a marker for an occult pelvic infection that may become PID (see below).
Septic Arthritis is also a rare problem, seen mostly in young, active and sexually active patients, most often attacking one major joint (most commonly a knee). Diagnosis is made by using a needle to drain pus from the affected joint, and then the bacterial is identified by a combination of Gram staining and culture. High dose antibiotics, probably intravenously, will be needed. In severe cases, the joint will need to be surgically opened, and washed out, possibly repeatedly.
Urethral scarring producing strictures was a common problem in the 1630s, mostly in males, requiring the passage of smooth, tapered metal probes called "sounds" on a repeated basis to allow the afflicted male to empty his bladder. Similar scarring of the epididymus may cause sterility.
PID is a serious enough complication of gonorrhea and Chlamydia, to warrant a separate discussion below.
Infected adults who do not practice good personal and hand hygiene can contract a rather nasty eye infection from gonorrhea. Similarly, a baby born to a woman with an active infection is at risk for serious eye infections. Both cases can be treated with several days of antibiotic eye drops, usually of chloramphenicol or tetracycline. At least early in the 1630s, silver nitrate drops will be more useful for treating newborns, as it is more stable and easier to keep sterile and fresh in field situations.
This infection is caused by an obligate intracellular bacteria known as Chlamydia trachomatis. In this time line, chlamydial infections were differentiated from gonorrhea only after reliable culture methods for the gonococcus were developed. Chlamydia only infects specific types of cells, but can enter the body either through the mucus membranes or through breaks elsewhere in the skin. Several types of chlamydial infections are known, depending on the area of the body that is afflicted.
Urethritis is perhaps the most common form and, like gonorrhea, is somewhat more commonly diagnosed in the male partners in the absence of up-time testing. Again, males tend to display problems, in this case with a mild discharge and occasionally painful urination. Tragically, women rarely show significant signs or symptoms until much damage has been done in the form of PID. As with gonorrhea, the best way to determine if a woman needs treatment is to check her male partners and treat all of them. When the technology levels allow a resumption of "routine pap and pelvic" exams, screening for both gonorrhea and chlamydia will produce a surprising number of cases.
The second most common form is trachoma, an infection of one or both eyes that is still a leading cause of blindness in Third World countries, accounting for some 15% of world wide blindness in 1995. This can occur as a neonatal infection, may be sexually transmitted, or may be associated with poor hygiene, either from a lack of hand washing or from flies that carry the infective organisms.
Perhaps the most serious form in men is Lympho Granuloma Venereum, or LGV. (The most serious form in women is PID, see below) In the US and Europe in OTL, the type of Chlamydia that causes this infection is much more rare than the form that causes urethritis. It is more commonly seen in the Third World, and as a result, may be expected to be more common in the 1630s. As an acute disease, LGV is easily confused with several other infections, including plague.
The first stage of LGV is a painless ulcer that may be mistaken for chancre if it is noticed, but the sore is only seen in 1/3 of men, and even fewer women. In the second stage of LGV, in most males but only in 25% of females, swollen inguinal lymph nodes occur that may be mistaken for plague buboes, especially if they become abscesses. Female cases usually (75%) have the swollen nodes in the intra-abdominal node chains, which do not tend to become abscesses. Other signs and symptoms of advancing disease include rectal inflammation and often abdominal masses and pain.
There will probably be no definite diagnosis available until the 1640s or 1650s, as culture is difficult and serology testing moderately complex even by current standards. This means that the diagnosis is one of exclusion, or you must treat on history and suspicion. Exclusion points for LGV include lack of treponemal forms in scrapings of the ulcers, "sterile" aspirates from the swollen lymph nodes (no bacterial seen on Gram's staining, nor do any bacteria grow when the pus is cultured), and that this disease, untreated, rarely results in death as compared to bubonic plague.
A large percentage of cases will show spontaneous resolution without treatment, and with only a small chance of future recurrence. Cases that are more serious may need drainage of abscesses, which may also lead to spontaneous resolution. This drainage is best done by inserting a needle into the abscess, rather than cutting it open, which may lead to severe scarring. Medications including chloramphenicol, sulfas, and when available, tetracycline class drugs, are all effective in treating this disease; however, the course of therapy may extend to as much as three weeks. Currently, tetracycline class antibiotics are considered the drug of choice, due to the potential side effects of the others.
Unlike ocular gonorrhea, silver nitrate drops are not effective for the treatment of chlamydia. The use of chloramphenicol or sulfa eye drops is effective and quite safe even in small children and infants
Latex condoms are somewhat effective in preventing the transmission of chlamydial infections. However, as with syphilis, the infection can enter the body through small cuts or abrasions in the skin as well as through mucus membranes.
See PID in the next section. The relatively mild chlamydial urethritis can result in epididymitis in males and reactive arthritis in both men and women. Reactive arthritis is more common in men than women, and involves a low grade fever, inflammation of the eyes, and one or more joints, more commonly of the lower body. Unlike the gonococcal arthritis, aspiration of joint fluid shows only white blood cells, and no evidence of infection. In this time line, Fitz-Hugh Curtis syndrome is now more often associated with a chlamydial infection than with gonorrhea, but this may be true due to missed co-infections. Up to 5% of patients with LGV may suffer from urethral or rectal strictures or peri-rectal fistulas. Neonatal infections may include a nasty pneumonia as well as eye infections. This is one of the few reasons to use silver nitrate drops for the prevention of eye infections in newborn infants, as any silver nitrate treated infant with an eye infection that persists for more than 48 hours after birth should also be treated with systemic antibiotics for a chlamydial infection. This is to prevent the chlamydial pneumonia that might otherwise show up one to three months after delivery.
Pelvic Inflammatory Disease is a serious and potentially life-threatening infection of women, usually associated with un- or under-treated Gonorrhea or Chlamydia.
In this time line, any female with a history of exposure to any previous episode of STI, especially with a long and/or varied history of sexual activity, and no good evidence of cure after appropriate treatment is at risk for PID. Even without this history, any non-virgin female with the typical physical exam findings of: the shuffle (where the patient takes small shuffling steps to decrease the pain of movement), fever, lower abdominal or back pain, pain on "intimate" examination, and a lower abdominal mass is considered highly likely to have PID. The diagnosis is not absolute, as similar findings occur in appendicitis, tubal pregnancy, and even severe ovarian cysts. Since three of the four primary diagnoses can become life threatening in a frighteningly short time, appropriate care needs to be started rapidly. This will include consultation with Dr. Nichols or one of the other surgeons.
Cultures of abscesses will probably show many types of bacteria, and anaerobic cultures are needed as well. White blood counts will be elevated, sometimes to very high levels (normals are 4,000 to 10,000 cells per cubic millimeter; PID can show between 15,000 and 30,000).
Initial treatment is with high doses of intravenous antibiotics, probably starting with a combination of chloramphenicol and penicillin in the 1632 timeline. Metronidazole (a deceptively simple synthetic antibiotic that probably will not be available until the late 1630s or early 1640s) is also helpful. Cephalosporins, when available, will have good effects. However, any moderate to severe cases will probably require surgical drainage of abscess and for the removal of scar tissue. As there are three major and one minor conditions that have many of the same signs, surgery is also the only way to make the definite diagnosis. Exploratory surgery also treats the other two life-threatening conditions if one of them is found instead.
Mild cases of PID will often result in tubal scarring with the attendant problems of sterility and a marked increase in the chances of tubal pregnancy. There is also a chance of Fitz-Hugh Curtis syndrome. The scars can also result in problems with twisted ovaries, uncomfortable as a minimum, and the source of future problems as well. More serious cases, as noted above, can result in tubal/ovarian abscesses, and even death from an associated ruptured tubal pregnancy.
Several different bacteria in the mycoplasma/ureaplasma group can also cause mild urinary tract infections in both men and women. Diagnosis is similar to that for Chlamydia, as is the treatment. Many cases resolve spontaneously. Generally, there is no sequale to untreated infection, just misery. NGU is mentioned because it can sometimes mimic the more serious infections.
Ectoparasites include crab or pubic lice, body lice, and head lice, all of which should be well known in the 1630s. Probably less well known would be the intradermal parasite known as scabies in our time line. The diagnosis is made by finding unexpected livestock on body or in clothing, by finding typical bite marks in areas of the body, by finding the burrows of scabies, or by finding the eggs (nits) attached to the hair.
Treatment in the 1630s will be initially with DDT dusting of sleeping quarters, disinfecting clothing with the use of DDT or steam laundry, and the use of fine-toothed nit combs on hairy areas of the body. Some groups will prefer to shave those areas to help reduce the chance of passing the infestation around. Oddly enough, the Roman technique of using olive oil as a precursor to bathing might have helped control lice, as medium weight oils (vegetable oil, light mineral oils) can be effective at killing the adult lice by smothering the critters.
Gamma Hexane (formerly Benzene) Hexachloride (GHH or Lindane) is cheap and relatively simple to make once the coal plants are turning out benzene. Like DDT and Chloramphenicol, it can be used with relative safety, at least by 1630's standards, although there are waste compounds associated with the production of GHH that are much more toxic to mammals, and much less toxic to insects. Canon has it starting in the winter of 1633-34 by the Essen Chemical Company. As with DDT and chloramphenicol, its use in this time line has been restricted because we have safer, less persistent alternatives. GHH is effective when used as shampoo for hairy areas in the treatment of lice or as a lotion for non-hairy areas in the treatment of scabies, but has age limitations and should only be used on intact skin.
The use of pyrethrum derivatives (from chrysanthemums) along with piperonyl butoxide can be expected in the mid-1630s time frame as a safer treatment for most forms of arthropod infestation. The exact timeframe will depend on the growth of sufficient chrysanthemum plants and sassafras trees to supply the needed precursors. This combination is most effective in the form of shampoos and lotions similar to Lindane, but is safe enough to use on infants and on irritated skin. Additionally, the flowers, dried and powdered, make a decent pediculcidal powder for use in linens, clothing presses, and on clothing itself. This is well within the capabilities of most of the herb wives once the flowers are grown in sufficient quantities.
Body lice are known to carry a number of different diseases that have been touched on elsewhere. The others are more benign.
There are a number of other sexually transmitted infections which exist in this time line. Among them are the bacterial infections of Donovanosis, and chancroid, the viral infections of herpes (two types, as well as other, related infections), warts, and hepatitis (five types, three of which also affect the blood bank), and assorted fungal skin infections. There are also several infections associated with pregnancy and childbirth that have significant effects on both the mother and baby. I'll cover these in a separate article, as the impact most of them have is less than the ones I have already discussed. The impact of aseptic technique on childbirth is worth an article on its own.
There was one known case of HIV in Grantville at the time of the Ring of Fire, who deceased shortly thereafter without transmission. (Venus and Mercury, Grantville Gazette 24) By authorial fiat, there will be no transmission of the T-cell Lymphocytic virus from African monkeys to humans in the 1632 universe.
Any other common infections (such as influenza, the common cold, strep throat, and various skin infections) are more easily transmitted by the close, intimate contact involved in sexual intercourse.
Diseases of childhood will be discussed in another article.
Guiding principle 1: The most important risk factor for any particular sexually transmitted infection is the presence of any other sexually transmitted infection, especially in patients who do not fit the typical "rakehell" profile. Patients who fit the "rakehell" profile should be considered to have AT LEAST ONE sexually transmitted infection any time they are evaluated. (Sorry, Captain Lefferts!)
Guiding principle 2: Intimate contacts of a known case must be tracked and treated, and all of their contacts must be tracked and treated as well. In this time line, there have been many studies showing that one missed contact can start the whole process all over again, and that there is often more to a "social circle" than just crumpets for high tea.
Guiding principle 3: Even without the hazard of HIV, any sexually transmitted infection that produces open sores markedly increases the chances of transmitting or catching any other sexually transmitted infection. Patients with known chronic, untreated or incurable sores must be followed closely. (See GP 4 below)
Guiding principle 4: Dr. Abrabanel takes the lessons from And the Band Played OnVERY seriously. Public Health measures do not need to include demonization of particular life style choices, but rather education on choices that improve disease prevention. However, persons with known active disease who are not curable and who will not cooperate with appropriate measures to prevent transmission to other persons should be dealt with appropriately. Certainly some authorities prior to 1631 are already proven (with the Scots Grandgore Act of 1497 as an example) to be willing to forcibly isolate syphilis patients who were incurable at that time.
Public health measures contributed to a reduction in the spread of venereal infections starting in the mid to late 1800s, and made significant inroads into the infectious problem after the development of the germ theory and definitive testing in the 1870-1910 era. Note that period is well before effective treatments for most of these infections existed. These measures include, but are not limited to:
Prenuptial and prenatal testing for syphilis (and later Hepatitis B) in particular
Testing of the blood supplies for syphilis and Hepatitis B as the blood banks come on line and then tracking infected donors.
Contact tracking for treatment.
Physical quarantine of flagrant re-offenders to prevent further spread of disease.
Water purification/pasteurization to help break the waterborne cycle of infections including Hepatitis A, Giardia, and many other diseases.
Uncircumcised males are known in this time line to be at significantly more risk for both contracting and passing many of these infections, due to the more sensitive nature of the anatomy involved. Good hygiene (including washing under the foreskin) will help with this problem if circumcision is not an option. As this point was first noted in OTL in the 1930s, it will be interesting to see if circumcision penetrates the culture by the 1650s as it did in this time line in the 1950s.
I am indebted to Iver Cooper's work for this section. Iver saved me major amounts of time with the posting of Industrial Alchemy Parts III and IV to the Slush Pile.
Penicillin in and of itself is being produced in small amounts in the USE by 1634, and a small but apparently viable sample of a "high producing" strain has been passed on to a manufacturer in Cologne for further development. I expect that at least three forms will be developed. In OTL, they are known as Benzathine Penicillin, a long-acting, intramuscular form; Penicillin Potassium (Crystal Pen), a fast-acting form that is generally given intravenously; and Penicillin VK, a fast-acting form that is suitable for oral administration. While penicillin allergies are among the most common allergies reported (totaling about 10% of all allergies), true penicillin allergies are relatively rare, and there are techniques available in the up-time information for overcoming this problem if penicillin is needed to treat a particular infection.
Probenicid is an organic acid that competes with the penicillin class and other drugs for excretion through the kidneys. This competition for excretion increases both the level and the time duration of the penicillin class drugs in the blood stream. A substituted benzoic acid derivative, probenicid should be easy for various pharmaceutical manufacturers to make as soon as the coal tar recovery system is on line. It will be vital in extending the effectiveness of penicillin when it first comes on line.

Chloramphenicol is available in small amounts in canon as of 1633, and the formula and manufacturing information was passed on to the King in the Low Countries at that time. (Grantville Gazette II) Thiamphenicol has been advocated for use in the 1632 universe by some, but here in the US, this drug is limited to veterinary use. Research shows that thiamphenicol has been used overseas (particularly in Brazil) in humans for the treatment of Donavanosis and chancroid. That same research does show that there appears to be no evidence of aplastic anemia associated with thiamphenicol, but the absolute numbers of treated patients published is not enough to consider it safer. There is some question as to the relative effectiveness compared to the chloro form. The big questions then become, "what is the chance that there were veterinary stocks in Grantville at the time of the Ring of Fire?" and "Would someone recognize that it might be easier to make than the chloro form?'
Sulfas of various sorts are being produced in fair quantities by early 1633.
Metronidazole is another drug that will vastly improve the treatment of many diseases, not just STIs. Deceptively simple, it probably won't be available until the end of the 1630s. The antifungal azoles are more complex, related compounds, and will probably be available in early 1640.
Other antibiotic medications (the tetracycline group, the erythromycin group, the aminoglycosides, and the derivatives of penicillin known as cephalosporins) will probably have to wait for assorted American (both North and South), Polish, Ukrainian and Russian soil samples, and the further development of tech levels in the late 1640 and into the 1650 time frame. Iver also pointed out that most of them were serendipitous discoveries from various mold specimens, so the various fungal derived antibiotics may not be exactly reproduced compared to the structures known today.
Ultimately, the "venereal diseases" (sexually transmitted infections) are controllable with a combination of careful population surveillance, by prenuptial, prenatal and blood bank testing; breaking the chain of infection by treating both the index case and all intimate partners (where possible); and good hygiene with plenty of soap and clean water. Ultimately, quarantine for patients who are both chronically infected and unable or unwilling to avoid intimate contact with others must be considered. Treatments available will improve over the span of several years, as the knowledge of how to make chloramphenicol, penicillins and sulfa drugs start to spread across the continent.
Online medical dictionary: http://www2.merriam-webster.com/cgi-bin/mwmednlm?book=Medical&va=
Online medical encyclopedia: http://www.nlm.nih.gov/medlineplus/encyclopedia.html
Cooper, Iver: Industrial Alchemy, Parts III and IV, pending publication
"Venus and Mercury" Grantville Gazette, Volume 24
http://www.cdc.gov/std/treatment/2006/rr5511.pdf (This is the current version, however I have filtered the recommendations based on what would be available in the 1998-2000 edition, adapted to the 1630's tech base.)
Control of Communicable Diseases in Man, 14th edition 1985 US CDC
http://en.wikipedia.org/wiki/Sexually_Transmitted_Infection
http://www2a.cdc.gov/stdtraining/Self-Study/ (requires registration and professional status, sorry)
http://www.cdc.gov/STD/training/
The Travel and Tropical Medicine Manual, Second Edition, Section V, Jong & McMullen, Saunders 1995
Davis, BD; Dulbecco, R; et al, Microbiology, 2nd ed Harper and Row, 1973 (a common microbiology text book for laboratory, pre medical and advanced nursing students in the mid 1970s)
The Merck Manual of Diagnosis and Therapeutics, 17th Ed, Merck Research Laboratories, 1999 (centennial edition)
Merck's Manual of Materia Medica, Merck & Co, 1899